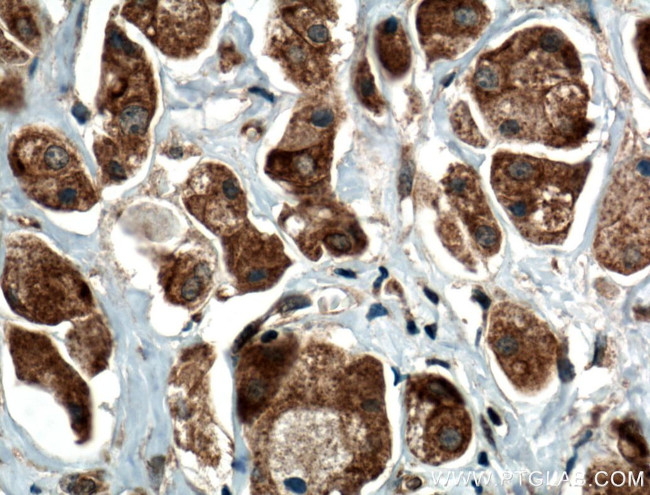
RARS Antibody in Immunohistochemistry (Paraffin) (IHC (P))

Search
Proteintech
RARS Polyclonal Antibody
{{$productOrderCtrl.translations['antibody.pdp.commerceCard.promotion.promotions']}}
{{$productOrderCtrl.translations['antibody.pdp.commerceCard.promotion.viewpromo']}}
{{$productOrderCtrl.translations['antibody.pdp.commerceCard.promotion.promocode']}}: {{promo.promoCode}} {{promo.promoTitle}} {{promo.promoDescription}}. {{$productOrderCtrl.translations['antibody.pdp.commerceCard.promotion.learnmore']}}
产品信息
27344-1-AP
种属反应
宿主/亚型
分类
类型
抗原
偶联物
形式
浓度
规格
纯化类型
保存液
内含物
保存条件
运输条件
产品详细信息
Immunogen sequence: MDVLVSECS ARLLQQEEEI KSLTAEIDRL KNCGCLGASP NLEQLQEENL KLKYRLNILR KSLQAERNKP TKNMINIISR LQEVFGHAIK AAYPDLENPP LLVTPSQQAK FGDYQCNSAM GISQMLKTKE QKVNPREIAE NITKHLPDNE CIEKVEIAGP GFINVHLRKD FVSEQLTSLL VNGVQLPALG E (1-190 aa encoded by BC000528)
靶标信息
The fidelity of protein synthesis requires efficient discrimination of amino acid substrates by aminoacyl-tRNA synthetases. ArgRS (Arginyl-tRNA synthetase), also known as RARS or DALRD1, belongs to the class-I aminoacyl-tRNA synthetase family that includes the related proteins, LeuRS, ValRS and IleRS. These proteins are large monomeric proteins and play a major role in catalyzing the aminoacylation of tRNA by their cognate amino acid. ArgRS localizes to the cytoplasm and exists as a monomer but can also associate with other tRNA synthetases and auxiliary proteins to form a multisubunit complex. In the presence of ATP, arginine (Arg) and tRNA, ArgRS joins Arg to tRNA(Arg) at its synthetic active site. Two cytoplasmic forms of ArgRS have been described in mammals, differing by the addition of a 73 amino acid sequence that is required for ArgRS assembly into the multisubunit complex.
仅用于科研。不用于诊断过程。未经明确授权不得转售。
生物信息学
蛋白别名: arginine tRNA ligase 1, cytoplasmic; Arginine--tRNA ligase, cytoplasmic; Arginyl-tRNA synthetase; arginyl-tRNA synthetase, cytoplasmic; ArgRS; MGC8641; Mutations: 1674:OK; unnamed protein product
基因别名: ArgRS; DALRD1; HLD9; RARS; RARS1
UniProt ID: (Human) P54136
Entrez Gene ID: (Human) 5917